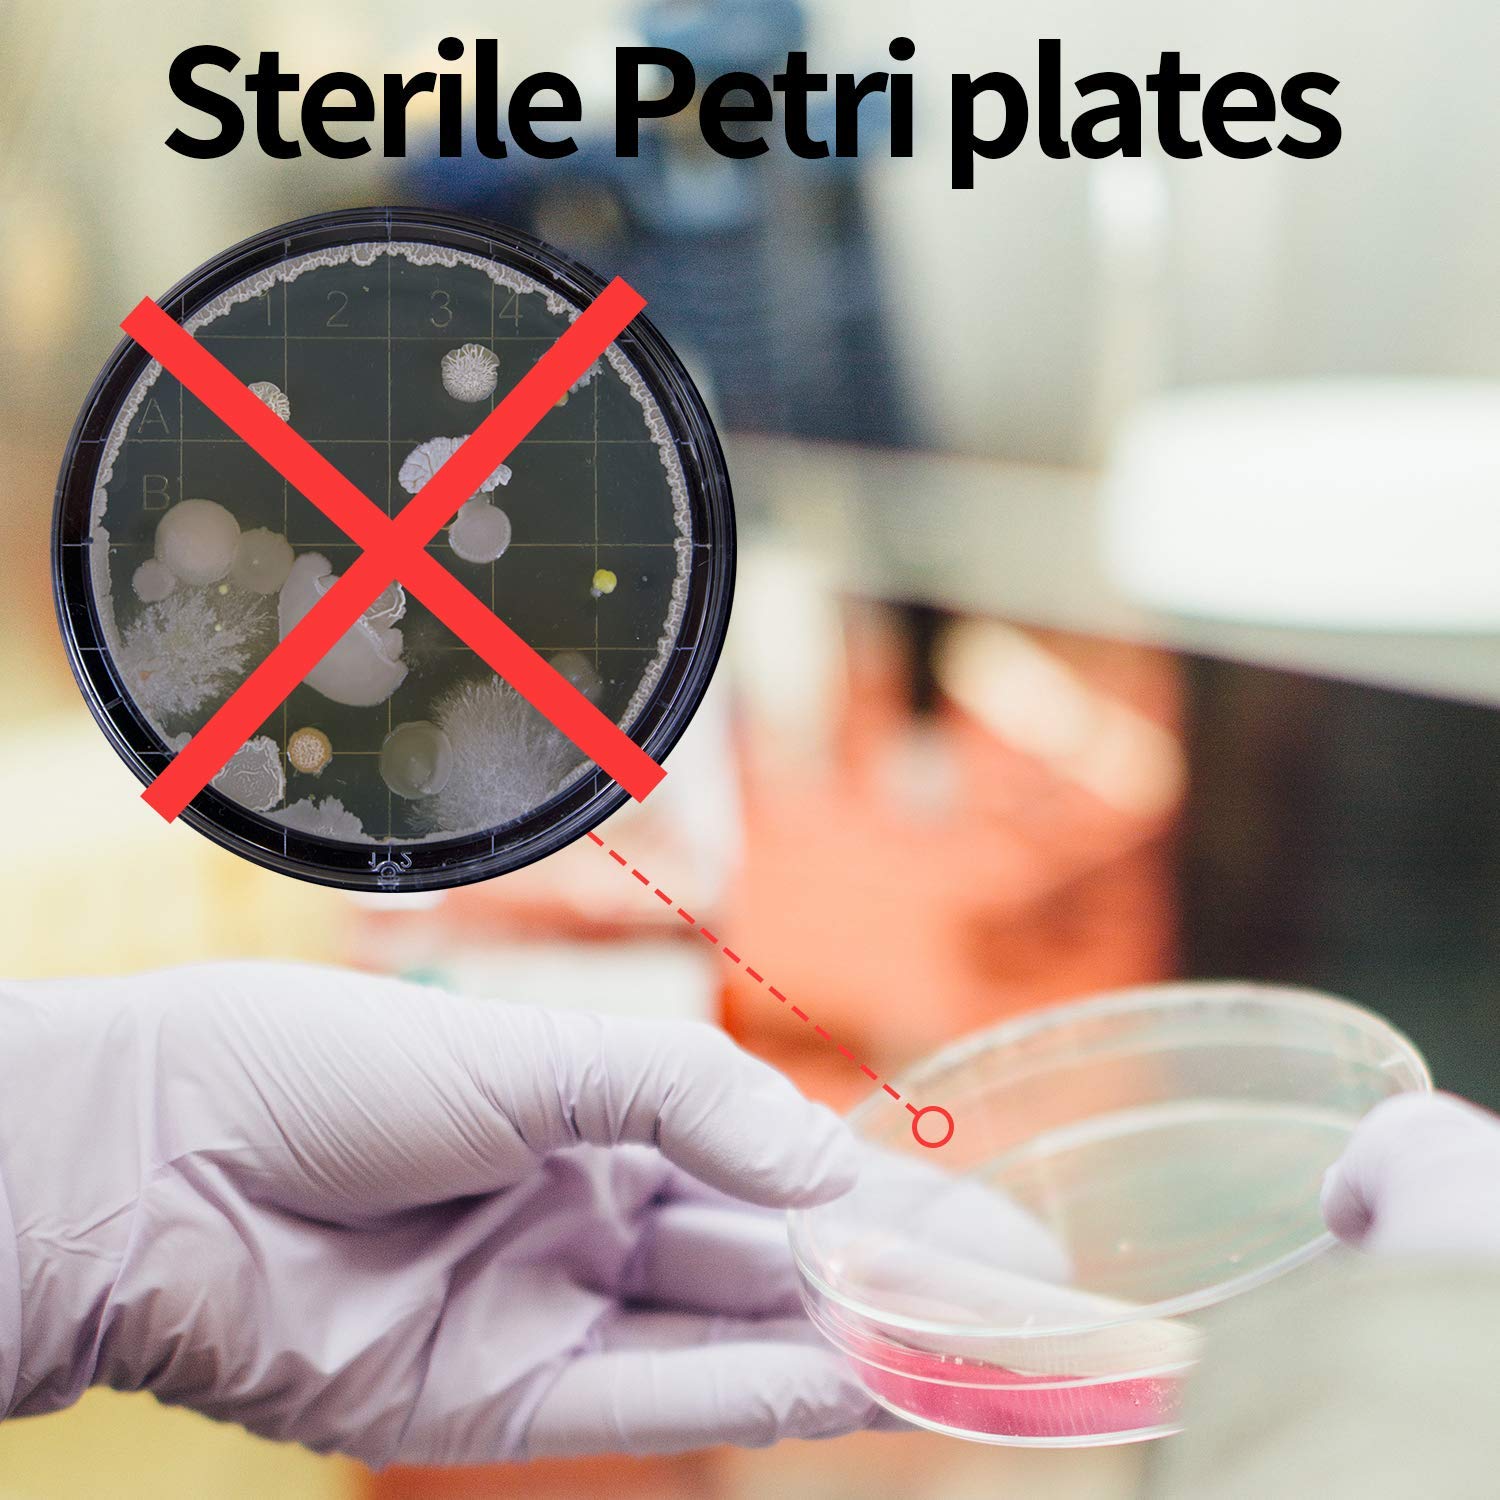
Piastre Di Petri 20 Sterilizzate 100x15 Mm Con Coperchio - Polistirolo, Per Laboratorio O Colture Set Piatti In Melamina - Foto 13

Piastre Di Petri 20 Sterilizzate 100x15 Mm Con Coperchio - Polistirolo, Per Laboratorio O Colture Set Piatti In Melamina
Disponibile
Disponibile
€ 3
AGGIUNGI AL CARRELLO
Consegna
- Corriere espressoda domenica 8 febbraioGRATIS
Venduto e spedito da ePRICE

Altri 4 venditori a partire da € 4
- Informazioni legali
- Ne hai uno da vendere?
- 551642
- 87492287074
Pensati per Te
Prodotti simili
Descrizione
Per ulteriori dettagli vedi l'inserzione., Brand: Allegiance, MPN: Does Not Apply, Material: Polystyrene Alternate Part number: Does not apply Applicable Regions: Does not apply, NSN: Does not apply Realizzate con materie prime selezionate (polistirolo cristallo 1a scelta) che assicurano la perfezione, la planarità e la trasparenza del prodotto; compatibili... Intended Use/Discipline: Biological Laboratory, Medical Laboratory, Microbiological Laboratory, Pathology, Physical Laboratory, Veterinary Medicine, Model: 100x15mm, Diameter: 100mm, Depth: 15mm, Custom Bundle: No Piastre Di Petri 20 Sterilizzate 100x15 Mm Con Coperchio - Polistirolo, Per Laboratorio O Colture Set Piatti In Melamina Persil Detersivo Nuovo: Oggetto nuovo, non usato, non aperto, non danneggiato, nella confezione originale (ove la confezione sia prevista). Item Condition: New other (see details), sku: SM-037663, UPC: Does not apply Modification Description: Does not apply Piastre Di Petri Monouso - Microbiologia E Istologia - Dispolab... Greiner Bio-One Piastre Petri in polistirene Non-sterile; VentedCaratteristiche e scheda tecnica
Caratteristiche principali
- EAN0781102887187
Recensioni
2026-02-01 | 6s59wrx